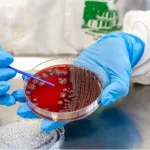

Médico alerta para o risco de pé diabético em pacientes
Descontrole da glicemia é o principal fator de risco No Dia Mundial do Diabetes, celebrado nesta quinta-feira (14), a Federação Internacional do Diabetes (IDF) alerta a população para uma das

Descontrole da glicemia é o principal fator de risco No Dia Mundial do Diabetes, celebrado nesta quinta-feira (14), a Federação Internacional do Diabetes (IDF) alerta a população para uma das

Garantida por lei, presença dos pais fortalece o vínculo e é importante para recuperação e alta do bebê. Entre janeiro e agosto deste ano, 11,93% dos 81.496 nascidos vivos no

Três países nas Américas ainda são considerados endêmicos para doença O Brasil recebeu nesta segunda-feira (11) o certificado de país livre da filariose linfática, doença popularmente conhecida como elefantíase. O

Atualmente, as normativas sanitárias para projetos básicos de arquitetura de estabelecimentos assistenciais de saúde e de interesse da saúde estão dispostas na Resolução Sesa nº 389 de 13 de junho

Encerram em 17 de novembro as inscrições para o curso “Saúde e Bem Viver: Cuidado Integral para a Saúde Mental”, ofertado pela Secretaria de Estado da Saúde (Sesa), por meio

Número de mortes após picadas passou de 92 para 134 em um ano A jornalista Ariane Póvoa, de 40 anos, enfrentou nesta semana um dos maiores medos que toda mãe

Lula sancionou hoje a lei que prevê pagamento de despesa de locomoção O presidente Luiz Inácio Lula da Silva sancionou a lei que prevê o pagamento de despesas de locomoção

Também foram registrados 104 surtos de doenças diarreicas agudas (DDA) no Estado. Transmissão ocorre por água e alimentos contaminados, contato com pessoas doentes e contato com animais. Boas práticas e

Em 2019 foram registrados 104,8 mil óbitos Um estudo divulgado hoje (5) pela Fundação Oswaldo Cruz (Fiocruz) mostra que o consumo de álcool causa, em média, 12 mortes por hora

O deputado federal Beto Preto votou a favor do Projeto de Lei 3449/24, que estabelece a isenção do Imposto de Importação para medicamentos destinados ao uso da pessoa física importadora.

Descontrole da glicemia é o principal fator de risco No Dia Mundial do Diabetes, celebrado nesta quinta-feira (14), a Federação Internacional do Diabetes (IDF) alerta a população para uma das

Garantida por lei, presença dos pais fortalece o vínculo e é importante para recuperação e alta do bebê. Entre janeiro e agosto deste ano, 11,93% dos 81.496 nascidos vivos no

Três países nas Américas ainda são considerados endêmicos para doença O Brasil recebeu nesta segunda-feira (11) o certificado de país livre da filariose linfática, doença popularmente conhecida como elefantíase. O

Atualmente, as normativas sanitárias para projetos básicos de arquitetura de estabelecimentos assistenciais de saúde e de interesse da saúde estão dispostas na Resolução Sesa nº 389 de 13 de junho

Encerram em 17 de novembro as inscrições para o curso “Saúde e Bem Viver: Cuidado Integral para a Saúde Mental”, ofertado pela Secretaria de Estado da Saúde (Sesa), por meio

Número de mortes após picadas passou de 92 para 134 em um ano A jornalista Ariane Póvoa, de 40 anos, enfrentou nesta semana um dos maiores medos que toda mãe

Lula sancionou hoje a lei que prevê pagamento de despesa de locomoção O presidente Luiz Inácio Lula da Silva sancionou a lei que prevê o pagamento de despesas de locomoção
Também foram registrados 104 surtos de doenças diarreicas agudas (DDA) no Estado. Transmissão ocorre por água e alimentos contaminados, contato com pessoas doentes e contato com animais. Boas práticas e

Em 2019 foram registrados 104,8 mil óbitos Um estudo divulgado hoje (5) pela Fundação Oswaldo Cruz (Fiocruz) mostra que o consumo de álcool causa, em média, 12 mortes por hora

O deputado federal Beto Preto votou a favor do Projeto de Lei 3449/24, que estabelece a isenção do Imposto de Importação para medicamentos destinados ao uso da pessoa física importadora.